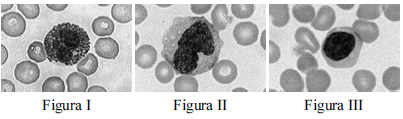
Enunciado 1174150-1

Foram encontradas 100 questões.
Acerca da bacteriologia médica, julgue o item a seguir.
Considera-se sinergismo a ação combinada de dois fármacos antimicrobianos, com atuação oposta no mesmo sistema, de tal forma que um iniba ou reverta o efeito do outro.
Provas
Acerca da bacteriologia médica, julgue o item a seguir.
A bactéria Treponema pallidum pallidum, causadora da sífilis, faz parte de um grupo de bactérias conhecidas como espiroquetas, que são microrganismos Gram-negativos longos, delgados, de forma helicoidal, espiralada ou em saca-rolhas.
Provas
Acerca da bacteriologia médica, julgue o item a seguir.
A supressão da microbiota normal cria um ambiente que tende a ser preenchido por microrganismos oportunistas, capazes de se tornar patógenos.
Provas

Tendo como referência as figuras precedentes, julgue o próximo item, relativo à hematologia.
No teste de antiglobulina humana, podem ser obtidos resultados falsos positivos por contaminação bacteriana da salina, centrifugação excessiva, ou na presença de células autoaglutináveis. Por sua vez, os resultados falsos negativos podem ocorrer quando o reagente antiglobulina humana é nãoreativo, em condições de incubação inadequadas ou quando, no teste indireto, o soro não é adicionado.
Provas

Tendo como referência as figuras precedentes, julgue o próximo item, relativo à hematologia.
Indivíduos que possuem antígenos D fracos não apresentam aloanticorpos anti-D, sendo identificados sorologicamente somente com o uso de antiglobulina humana ou enzimas.
Provas

Tendo como referência as figuras precedentes, julgue o próximo item, relativo à hematologia.
A quantidade das células representadas em destaque na figura I aumenta de forma acentuada no sangue durante as reações alérgicas e as infestações parasitárias. Sua diminuição pode ocorrer em casos de estresse agudo, queimaduras, inflamação aguda ou infarto do miocárdio.
Provas

Tendo como referência as figuras precedentes, julgue o próximo item, relativo à hematologia.
A célula representada em destaque na figura III é capaz de se desenvolver em grandes células fagocitárias, que podem ingerir bactérias e outras substâncias estranhas ao organismo. Seu aumento é identificado em doenças como tuberculose, carcinoma e infecções crônicas.
Provas
Tendo como referência as figuras precedentes, julgue o próximo item, relativo à hematologia.
A célula representada em destaque na figura II é importante nas respostas imunes específicas do corpo, incluindo a produção de anticorpos. Sua concentração aumenta em resposta imunológica a vírus, e a detecção de sua diminuição é mais provável quando se faz uma contagem diferencial automatizada ou contagens absolutas.
Provas
A respeito das análises microbiológicas da água e dos alimentos bem como sua legislação, julgue o item subsequente.
O processo de pasteurização do leite visa à obtenção de amostras livres de microrganismos patogênicos. Nesse processo, são destruídos as leveduras e os fungos filamentosos. Porém, esse processo é incapaz de destruir bactérias dos gêneros staphylococcus e lactobacillus.
Provas
A respeito das análises microbiológicas da água e dos alimentos bem como sua legislação, julgue o item subsequente.
Segundo o regulamento técnico sobre padrões microbiológicos para alimentos da ANVISA, RDC n.º 12, de 2 de janeiro de 2001, em amostras de carnes embaladas a vácuo, não maturadas, é permitida a presença de coliformes fecais na concentração de dez mil unidades por amostra indicativa.
Provas
Caderno Container